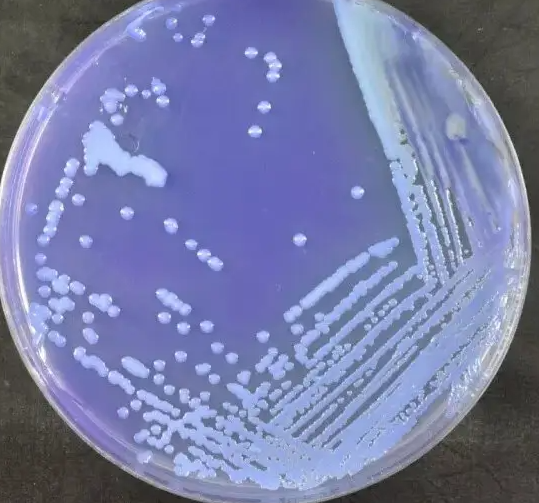
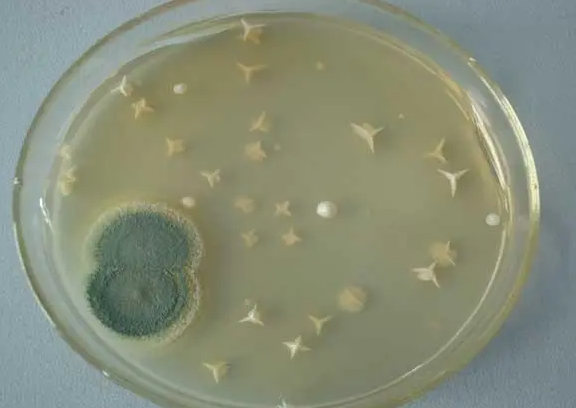

支付宝蚂蚁庄园每天都会有新的每日一题,大家知道今天的题目是什么吗?题目是:白色的糯米汤圆煮完了表皮变红还能吃吗?相信很多玩家都想知道答案吧,小编都给你们整理好了,不知道的玩家我们一起去看看吧,知道的玩家也拓展一下吧。

支付宝蚂蚁庄园2022年11月5日问题:
白色的糯米汤圆煮完了表皮变红还能吃吗
有风险,不建议吃
可以吃,掉色而已
答案:有风险,不建议吃
解析:这种变质的糯米粉,已经受到一种叫酵米面黄杆菌的污染。这种细菌一经加热即死亡,呈黄红色。食用发红的汤圆后,可能感到消化道不适,出现腹泻呕吐。
酵米面黄杆菌简介
酵米面黄杆菌(Flavobacterium farinofermentans nov.SP.)是新发现的食物中毒的病源菌。目前,世界各地由该菌引起食物中毒的报告尚罕见。我国东北、广西等地曾有臭米面中毒的报告(臭米面食物中毒的病源菌—1978年黑龙江省卫生防疫站定名为产毒黄杆菌,1979年由酵米面中毒病因研究协作组鉴定,暂定名为酵米面黄杆菌)。我省1981年首次发生于涪陵县黄旗、志韩两公社。经流行病学、细菌学、血清学调查,证实为酵米面黄杆菌中毒。

中毒应该怎么办:
酵米面黄杆菌中毒症状表现为呕吐、腹泻等急性胃肠炎,还可能是严重的肝功能损害、意识不清、抽搐甚至死亡。发酵米粉中毒称为椰黄假单胞菌发酵米粉亚种食物中毒,是因为将发酵米粉制成一种食物而引起的食物中毒。制作发酵米粉的原料有很多,如玉米、高粱米、小米等,将一种或两种浸泡在水中,浸泡时间随温度变化,会有不同程度的酸味。由于椰子假单胞菌广泛分布于外界环境中,在米粉长期发酵过程中容易被污染,在适当的温度等条件下能产生大量剧毒的酵母酸和毒黄素,对中毒者危害极大。中毒者可以使用碳酸氢钠溶液,二巯基丁二酸钠等进行药物治疗。建议在中毒后保证呼吸道通顺,做好基础的护理,保持良好的心态。
上面这就是就是小编整理的白色的糯米汤圆煮完了表皮变红还能吃吗的介绍,希望可以帮助到大家了解白色的糯米汤圆煮完了表皮变红还能吃吗,感谢大家的支持,如果想第一时间获取更多资讯,请关注小黑网。
百度贴吧简约版
青云志玲珑秘境
太空站塔防
怪物传说僵尸暴动
淘艺术
网易波波直播间
我的土豪梦
千魔烈斩